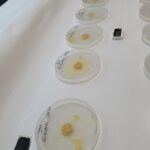

Fête de la Science au lycée Notre Dame le Ménimur du 07 au 17 octobre 2022
Au programme : ateliers, visites, conférences et exposition sur le thème du « Changement climatique : atténuation et adaptation ». Evènement exclusivement réservé aux lycéen(ne)s de l’établissement
- Lundi 10 octobre : conférence de Christian et Clara Dumard « Un père et sa fille défient le Pôle Nord à la voile », une aventure dans l’Océan Arctique – le travail d’un routeur météo
- Mardi 11 octobre : ateliers « Quel avenir pour le plancton ? » avec l’association « Cap vers la nature »
- Mercredi 12 octobre : atelier mission « Energies et climat » > découverte des modes de productions de l’électricité, comprendre le lien entre énergies et climat et réduire les émissions de gaz à effet de serre. Les élèves co-construisent des solutions
- Jeudi 13 octobre : atelier / manipulation « Qualité de l’eau et biodiversité » avec l’association « Eau et rivières de Bretagne » à Locqueltas
- Vendredi 14 octobre : atelier le « Blob » à l’Université Bretagne Sud (Vannes)
Atelier ADN à l’Université Bretagne Sud
Atelier plancton
- du 7 au 17 octobre : exposition de la Cité des Sciences et de l’Industrie « Regards sur le littoral » par Armor Science, centre de culture scientifique et industriel au CDI du lycée
- du 7 au 17 octobre : exposition sur la génétique à la médiathèque du Palais des Arts
- Après les vacances de la Toussaint : Intervention de Marie-Anne Cambon, chercheuse en écologie microbienne et symbioses spécialisée dans les grands fonds, à l’Ifremer de Brest. Echanges sur la protection et fonctionnement des écosystèmes profonds
> Plus d’informations sur la Fête de la Science en Bretagne